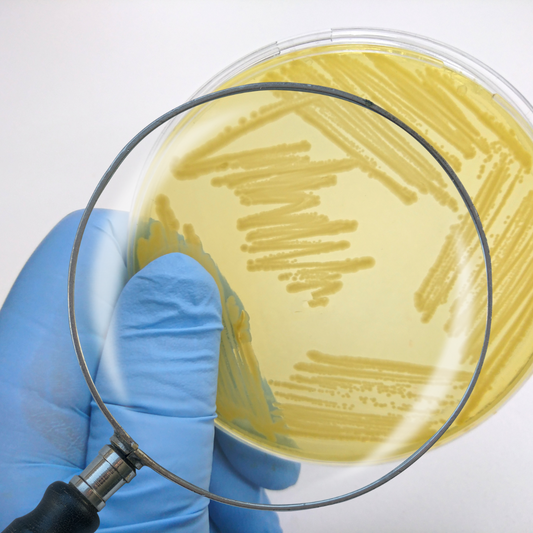

BEAUTY BLOG
ほうれい線やお口周りのシワ取り
ほうれい線の悩み ほうれい線とマリオネットラインの左右差に悩み、マウスピースを使われている方もいるとのお話しを耳にしました。食いしばりや顎の歪みが気になる方、寝ている間も顔面筋、特に「咬筋」が緩む時がないので、マウスピースを使い顔面筋を緩ませるのも良いらしいです。 そして筋肉と顎関節に力を抜く練習にもなります。 これだけでも繰り返していけば、過緊張の筋肉が緩み、ほうれい線や口周りのシワ取りのサポートになると思われます! 何事も、日々継続ですね! シワをふせぐには乾燥からお肌を守ることが大切です。 SiMPLE++で肌対策してみませんか? 商品全てをお試しいただけえるのは 1weekトライアルキット です。
エラは筋肉ですよ!
エラの正体はわかりますか? エラの正体はわかりますか?→「肥満化した筋肉」なのです。 骨ではありません。 そして、、、 エラ張りは生まれつきだと思っていませんか? 実はエラは骨ではなく、深部と浅部の2種類が重なった「咬筋」という筋肉が噛み癖や食いしばりにより、分厚くなっているのです。 食いしばりはいつも咬筋を筋トレしている状態ですから、筋肉が肥大化してエラが張って見えるのです。 例えば、マッサージが内側から外側へではなく、音側から内側への逆マッサージでほぐしていけば、エラの張りが取れて四角い顔が卵型に変わる事があります。咬筋の使いすぎでエラがはり、そのまま放置しておくと筋肉だけではなく骨格も下に落ちて広がります。幅広い顔になり、口角も下がります。 マッサージが有効? 私は常に咬筋、前頭筋、側頭筋にアプローチは必要かもしれませんね。 「常に美を追求」していくのは容易いものではありませんが、何事も継続が大事ですね。
目の下のクマの改善方法
目の下のクマはなぜできる? 目の下のクマは顔色が悪くみえてしまいますよね。 改善できるのであればぜひ試してみたいです。 クマの種類は3種類 ①茶クマ メラニンによる色素沈着によって出来る。紫外線や摩擦による刺激、メイクの落とし残しなど、年齢を重ねるうちに茶くまがおきやすくなります。[改善方法]保湿、美白ケア、目元を擦らないようにしましょう ②青クマ 目の周りの血行不良によって出来る。寝不足になると血行不良を起こしやすいので、ね不足の時に出来るくまです。[改善方法] 血行よくする為に蒸しタオルなどで目元を温めましょう!目元マッサージも効果的 ③黒クマ 目の下のたるみやくぼみによる影が原因で出来るクマです。 年齢と共に目元の筋肉が緩んでくると、眼窩脂肪と呼ばれる脂肪が前に出てきてしまい、目の下に影を作ってしまうのです。[改善方法] 眼窩脂肪が前に出て来てしまう事で出来てしまうので、ホームケアで出来る事は少ないです。 混同している場合もありますので、茶クマ、青クマケアを行なってみてください。 お肌のお手入れも顔のトーンがあかるくなりますよ。 SiMPLE++のメゾットで肌をリセットしてみませんか? 商品全てをお試しいただけえるのは 1weekトライアルキット です。
顔の老化は歪みが原因
顔の歪み 顔の歪みは少しづつすすみます。 ストレスによる食いしばりや噛み癖で顎が歪み、顔のトラブルを起こしている人も少なくありません。 全ての顔の悩みは、顔の筋肉の問題かと思います。 姿勢が悪く食生活が乱れていて、水分を余り摂らない=顔がたるむ、シワが増える、ハリがなくなる。 猫背の人は99.9%顔がたるんでいるそうです。どんなに高級な美容液を購入してもフェイスケアに力を入れていても、猫背のままでは顔の老化が止められないそうです。 顔と体は筋膜という1枚の膜でつながっているから! 猫背だとその背中から頭へと繋がる筋膜が伸びきってたるんだ状態ですから、筋膜も下へ伸びてたるみます。 逆に姿勢を正せば背中から筋膜が引っ張られ顔もリフトアップするのです。健康な腸は美肌に不可欠な要素であり、腸の調子を整える事でシワやたるみが出来にくくなります。 体の内側からキレイになりましょう。
美容成分が同じなら効果も同じ?
美容成分が同じでも“呼び名“が異なる 美容成分が同じでもメーカーのよって“呼び名“が異なる事があります。 化粧品と医薬部外品の表示名称が異なる事があるそうです。 ルールを定めている期間が違う為化粧品は原則、日本化粧品工業連合会が作成するリストを用いて記載。一方医薬部外品は厚生労働省に薬事申請した名称で表示。 2つの間で名称が統一されていない その2つの間で名称が統一されていないだけだそうです。 表示名称が違いますが、働きは一緒なので気にしなくてもいいかも知れません。 成分が同じでも処方次第で別物になります。 成分表示表の並びは、化粧品に1%以上含まれる成分は濃度の高い順に並び、それ以外の順番は自由。 また、医薬部外品は有効成分以外を表示するという義務はないそうです。 成分表に同じ成分が同じ順で並んでいても、含有量は異なる為、効果にも違いがあるそうです。 例え同じ成分でも、処方が変われば効果は全く違うものになります。 原液コスメに明確な定義は存在せず、濃度に関してはメーカーや製品によって異なります。固形や粉末状の原料(有効成分100%)の使用感や効果を高める為に水をはじめ色々な成分を含んでいるので100%有効成分ではないそうです。 ただ、濃度の追求に有効性が期待出来る物もあるそうです。 SiMPLE++で肌をリセットしてみませんか? 商品全てをお試しいただけえるのは 1weekトライアルキット です。
ニキビができる原因と部位について
体調を知る事が出来る反射区とは? ニキビが出来る部位で体調を知る事が出来る反射区というものがあります。 スキンケアや環境の変化などによる肌トラブル、ホルモンバランスの乱れなど・・・ ○おでこ 胃腸が弱っている・ストレス・シャンピーやメイクの洗い残し ○頬 食生活の乱れ・血行不良・ホルモンバランスの乱れ・紫外線の影響によるトラブル ○顎やフェイスライン 婦人科系(ホルモンバランス)の不調・マスクによる蒸れ・体の疲れ・寝不足 そしておでこの生え際にニキビができ始めた時、ストレスと疲れが原因。 胃腸が弱っている時は口周り(特に唇の近く)にトラブルが起きやすいです。 もしニキビが出来てしまったら、それは体からのサインだと思い、根本の原因から対処していきましょう。 SiMPLE++で肌をリセットしてみませんか? 商品全てをお試しいただけえるのは 1weekトライアルキット です。
美容液と化粧水どちらが先?
順番は一緒? 化粧水→美容液→乳液の順番が基本スキンケアーに欠かせない3つの基本アイテムですが、製品によって推奨する順番が変わるものもあります。 洗顔後、美容液を1番につける方もいます。 最後はクリーム系のようです。 そして時間が経ち、乾燥が気になるようでしたら、更に保湿効果のあるクリームか美容液を入れ込み二重三重にしないと乾燥がひどい方もいるとのこと。 加えて朝までつけて置けるパックがあり、それをつけて寝ることもあるそう。 乾燥がひどいときは、こういったやり方もあるですね! 皆さん肌には個人差がありますので、ご自分のベストなやり方をチョイスされるといいと思います。 シンプル++ モイストローション はミニマムな成分設計で、限りなく純水に近づけた化粧水。肌本来の保湿力を高めます。
ニキビと体の不調
大人もニキビに悩まされる 若さの象徴と言えるニキビですが、意外にも大人ニキビに悩まされている方も多いです。 場所による不調 ニキビが出来る場所によって体がどんな不調が出ているかわかります。 ●おでこ 胃腸の不調や消化機能の低下が原因かも知れません/ 食生活の改善が効果的●頬 便秘や胃腸の不調/糖質や脂質を控える●顎 生理前に影響が出やすい/ 肌の代謝が崩れている可能性がある/ お風呂で体を温める●背中 シャンプーなどの洗い流しや乾燥が原因/ 皮脂が多く分泌するので清潔に保つ事 もしニキビが出来てしまったら、それは体からのサインだと思い、根本の原因から対処していきましょう。 SiMPLE++で肌をリセットしてみませんか? 商品全てをお試しいただけえるのは 1weekトライアルキット です。
美肌と血行不良の関係
スムーズな血流って? 血流がスムーズだと栄養や酸素が体の隅々まで届き、老廃物は体外へと排出されます。しかし血行不良の状態だと栄養や酸素が行き渡らず、健康な細胞を作る力が低下。“血管の老化“コラーゲンなどのタンパク質で出来ている血管、加齢によりそれらが減ったり質が低下したりすると弾力を失い血液がスムーズに流れなくなります。乱れた食生活や運動不足、体の冷えが加わると血液がどろどろになり、更に血流の悪化を進める事になります。 日常生活で簡単に出来る改善方法 日常生活で簡単に出来る改善方法はリンパマッサージ、運動、入浴などです。 日々少しだけ気にしてみることで改善されるといいですね。
目の下がシワシワになる10のNG!
目元は皮膚が薄い為、トラブルが起きやすいパーツです。 以下のような仕草や行動は要注意!1)目をゴシゴシ擦る2)アイクリーム等を人差し指に力を入れてつける3)目の周りのマッサージを強く行う4)目の下の乾燥を放置する5)合わないコンタクトレンズをつけている6)目の下のクマを放置する摩擦と乾燥、そして血行不足が原因しています。目元は皮膚が薄い為、強く擦ったり触ったりする事でシワやたるみだけではなく色素沈着を招く可能性もあります。 合わないコンタクトレンズをつけていて、瞬きの回数が増え、目元の乾燥を引き起こします。 目の疲れや血行不良 目の疲れや血行不良により、シワを招くNG習慣です。 栄養は血液に乗って肌に供給される為、血行が悪いという事はそれだけで栄養が行き届かないという事です。 栄養不足の肌はハリが低下し、シワやたるみを引き起こします。 目の下のハリを保つ為に取り入れたい習慣 1)目元専用のクレンジング料を使用する 2)目の下はコットンパックで水分補給いかがでしたか? シンプル++ モイストセラム は特に乾燥が気になる箇所へお使いいただけます。
生理と美肌関係について
肌荒れが起こりやすいとき 生理前はニキビや出たり何かと肌荒れが起こりやすくなりますね。 今回はなぜ生理前に肌荒れをするのか?又どのようにケアするのか?ご紹介いたします。 [生理前] 妊娠に備えてくれるホルモン(黄体ホルモン)が増える事によって、浮腫や皮脂が増える。イライラなど心のバランスも乱れやすくなってしまいます。 この時期はお肌が敏感になっているので、グリセリンや油分が多い物、過剰なスキンケアは避けましょう。 カフェイン、甘い物、アルコールの取り過ぎにも注意です。 これらは皮脂をコントロールしてお肌の代謝を助けるビタミンB群を大量に消費してしまうので、多めにビタミン剤を取りましょう。 水分もこまめに摂ることがいいです。 [生理中] 血行が悪くなり体温が下がり冷えやすい状態になります。 お肌を守るバリア機能が下がり、乾燥したり敏感になります。 なるべく低刺激なものでしっかり保温しましょう。 首や腰、お腹を温めて血行を良くする事が大事です。 [生理後] 女性ホルモンがピークになり、エストロゲン(女性ホルモン)が増えてお肌の調子も良くなります。 新しく使いたい化粧品がある場合はこのタイミングがいいかも知れません。この時期は下半身を温めたりストレッチをしたり生理前に備えましょう。 SiMPLE++で肌をリセットしてみませんか? 商品全てをお試しいただけえるのは 1weekトライアルキット です。
入浴中に洗顔はNG?
入浴中にクレンジングしていませんか? シャワーの際、あなたは入浴中にクレンジングしていませんか? お風呂に入ると肌がふやけ、バリア機能は低下します。 少なからず刺激を与えるクレンジングは、入浴前に行うのがお薦めといわれています。 又、毛穴を労わる事にもつながるようです。 たるみ毛穴には、迷わずレチノールがいい! 加齢によるコラーゲンなどの不足で、真皮が弛んで毛穴が衰えたるんで毛穴が涙型にのびや状態をいいます。 エイジングケア成分であるレチノールは、コラーゲンやエラスチンの生成をサポートする成分です。 リンクルクリームに配合され下がった肌をリフトアップ。たるみ毛穴にも効果が期待できます。 SiMPLE++の モイストメイクアップ クレンジング は肌への負担に配慮し、保湿成分をふんだんに配合。保湿をしながら汚れを落とし、継続的にご使用頂くことで肌のバリア機能も高めます。 シャワーの際も使用できますので、ぜひ肌を優しくいたわりながらクレンジングをしてくださいね。
ファンデーションのパフには殺菌が8万個以上
ファンデーションのパフは洗っていますか? 肌の皮脂や水分を含んだパフにはアクネ菌やバクテリアなどが繁殖しやすく、たとえば一週間洗わないパフには約8万個の菌が繁殖するという実験結果があるそうです。 湿度が高く密封された環境なのでカビだらけになります。 肌にあるアクネ菌は常在菌として存在します。 アクネ菌の増殖と黄色ブドウ球菌が結びつくと炎症を起こし、赤ニキビになります。それに緑膿菌がつくと膿んだニキビになります。 洗っていないパフでファンデを塗る時は、菌を塗りつけているのと同じ。理想な使い方は、1面使ったら裏面を使い、そして洗う。何個かパフを持って、洗い替えを準備しておくのがいいでしょう。 おすすめな洗い方 クレンジングと一緒になった洗顔フォームをつけて洗う。 もしくはホワイト石鹸も、よく汚れが落ちると聞きます。 専用の洗浄剤なども市販であるようですね。 又、アイシャドウやチークに使う筆も、洗い替えの予備を用意しておくのもいいでしょう。 普段毎日使うコスメポーチも汚れチェックを忘れずに!
膝の黒ずみの原因と対処法
お肌のケアは顔だけではない 一度出来るとなかなか消えない頑固な“膝の黒ずみ“ その原因は衣類の摩擦による色素沈着や乾燥、溜まった角質などです。 スクラブも強く擦ると摩擦により返って色素沈着となり、又他のスクラブと次から次へと悪循環となる場合もあります。 脇や肘、お尻、ビキニラインの黒ずみはムダ毛処理の際、肌ダメージ&下着や洋服の摩擦が要因。 お顔だけではなく、体のお肌のお手入れ、角質ケアと保湿ケアも必要ですね。 やってはいけないNGリスト 1)肘、膝をついたり硬い椅子に長時間座ったり物理的にも気をつけましょう2)お風呂時間、ナイロンタオルのゴシゴシ洗い3)下着の摩擦にも注意4)無理なムダ毛処理も黒ずみの原因 エイジングは関係している? 代謝の善い、悪いが関係しています。 週1~3回でも膝にも美容液を! 膝、肘、踵、お尻、ビキニラインに化粧水と美容液をつけるのもよいですね。 特に膝周りはリンパの流れも代謝も悪い部位であるので、マッサージと美容液はお勧めです! 膝の黒ずみケアは、まず角質をオフ、その後にたっぷり潤いを与えましょう。 角質ケアは温感スクラブジェルやナチュラルピーリング効果のあるジェルなどもお勧め。関節を曲げてシワを伸ばして行うのがポイントです。 又、保湿不足で黒ずんで見える事もあります。 ぜひ、皆様気になる黒ずみ改善に向けてお顔と同じケアをしてみてはいかがでしょうか。 SiMPLE++の商品は全身にお使いいただけます。 まずはローションと乳液からのケアもいいかもしれませんね。 シンプル++ モイストローション はミニマムな成分設計で、限りなく純水に近づけた化粧水。肌本来の保湿力を高めます。
気になる目の左右差
皆様、目は左右対象ですか? 悩まれている方が多いとよく耳にします。その原因としましては、横向いて寝た時、下になった方に脂肪、老廃物、流れ重力の重みで顔全体がたるみ、目の左右差に繋がります。眉毛を寄せたり表情を作る時など、眉毛をよく動かす癖が多い方はおでこや頭が凝りから目を小さくするだけではなく、左右差が出る原因になります。 姿勢も影響します 姿勢が丸くなると、肩、首が凝ります。 次に頭が凝り、おでこが凝って目が小さくなる原因になります。座る姿勢により骨盤がズレ体の左右差から目の左右差の原因になります。 目の左右差対策 ※仰向けで寝る※眉間にシワを寄せない事を意識する※姿勢を意識して気をつける癖って、蓄積されてどんどん筋肉は凝ってくる為、目の左右差だったりお顔の悩みは進行していきます。 そうなると時間もかかるため、まずは日常生活での出来る対策を見直しましょう。今の目の左右差を改善するには、お顔の筋肉をほぐす事で固くなった筋肉が柔らかくなり、目の左右差が改善していきます。※筋肉は使いすぎても使わなすぎても、どんどん凝っていきます。